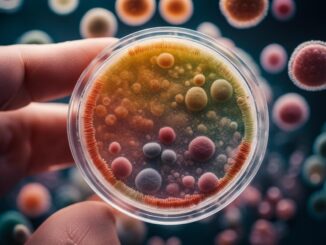
example 410

Russie contre transfert F-16 Ukraine
À l'approche du sommet de l'OTAN, prévu à Washington du 9 au 11 juillet, la Russie intensifie considérablement ses pressions militaires sur Kiev en menant de nombreuses attaques contre ses bases aériennes. Selon plusieurs analystes, cette montée de tension est…